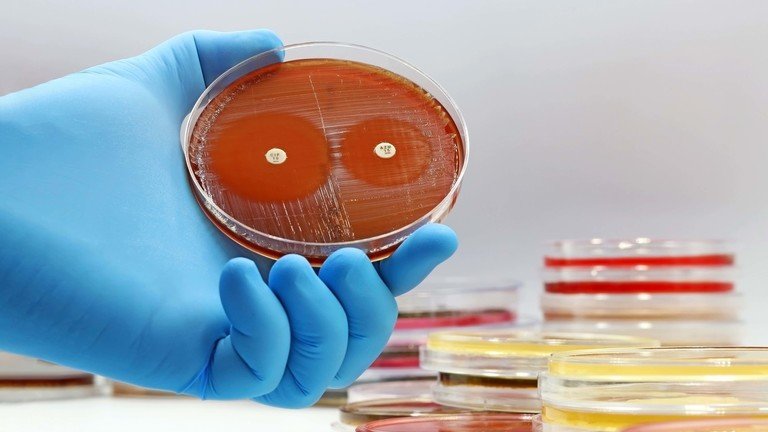

Bota rrezikon të kthehet në epokën para zbulimit të penicilinës, kanë paralajmëruar mjekët gjermanë, duke vënë në dukje rritjen e patogjenëve rezistentë ndaj antibiotikëve.
Penicilina, e zbuluar në fund të viteve 1920, zgjati jetëgjatësinë e njeriut deri në 30 vjet duke luftuar shumicën e infeksioneve bakteriale, sipas gazetës Bild. I gjithë ky përparim thuhet se tani është në rrezik.
“Aktualisht jemi duke humbur arritjet e mjekësisë moderne dhe po kthehemi në kohën para zbulimit të penicilinës”, tha për Bild Mathias Pletz, kreu i shoqatës “Paul Ehrlich për Terapinë e Infeksioneve”.
“Antibiotikët ishin arritja më e madhe e mjekësisë ndonjëherë,” tha profesorja Yvonne Mast, një mikrobiologe dhe studiuese në Institutin Leibniz në Braunschëeig.
“Fakti që tani po shfaqet gjithnjë e më shumë rezistencë dhe mungojnë antibiotikët e rinj është një kërcënim i madh.”
Gazeta gjermane citoi një studim që vlerësoi deri në 39 milionë vdekje në mbarë botën deri në vitin 2050 për shkak të patogjenëve rezistent ndaj antibiotikëve. Infeksione të tilla tashmë përbëjnë 35,000 vdekje në BE çdo vit.
Sipas profesorit Frank Brunkhorst të Spitalit Universitar të Jenas, një nga arsyet është se mjekët rekomandojnë më shumë antibiotikë për procedurat ambulatore. Për shembull, antibiotikët janë të padobishëm kundër pothuajse të gjitha infeksioneve të rrugëve të frymëmarrjes, të cilat shkaktohen nga viruset.
“Së dyti, shumë mikrobe rezistente po vijnë tek ne për shkak të udhëtimeve ndërkombëtare, të cilat po lulëzojnë përsëri pas Covid,” tha Brunkhorst, duke treguar për shtamet rezistente “veçanërisht në vende si Greqia, Portugalia, Turqia, por edhe në Indi dhe vende të tjera aziatike”.
Ai paralajmëroi gjermanët që kthehen nga pushimet se mikrobet që ata sjellin mund të jenë “kërcënuese për jetën” për gjyshërit e tyre.
Industria mjekësore ka qenë e ngadaltë në zhvillimin e antibiotikëve të rinj sepse hulumtimi është shumë i gjatë dhe shumë i shtrenjtë, ndërsa fitimet janë shumë të ulëta, sipas profesor Mast. Vetëm 12 medikamente të reja janë miratuar që nga viti 2017, tha ajo.
Vetëm një në 5000 substanca arrin pjekurinë e tregut, periudha e zhvillimit është diku nga 8-15 vjet dhe kostot e R&D mund të shkojnë deri në 2 miliardë dollarë, sipas Mast. Ajo kërkoi më shumë fonde për kërkime dhe miratime më të shpejta, duke vënë në dukje se Kina tashmë ka kaluar Gjermaninë në këtë fushë.